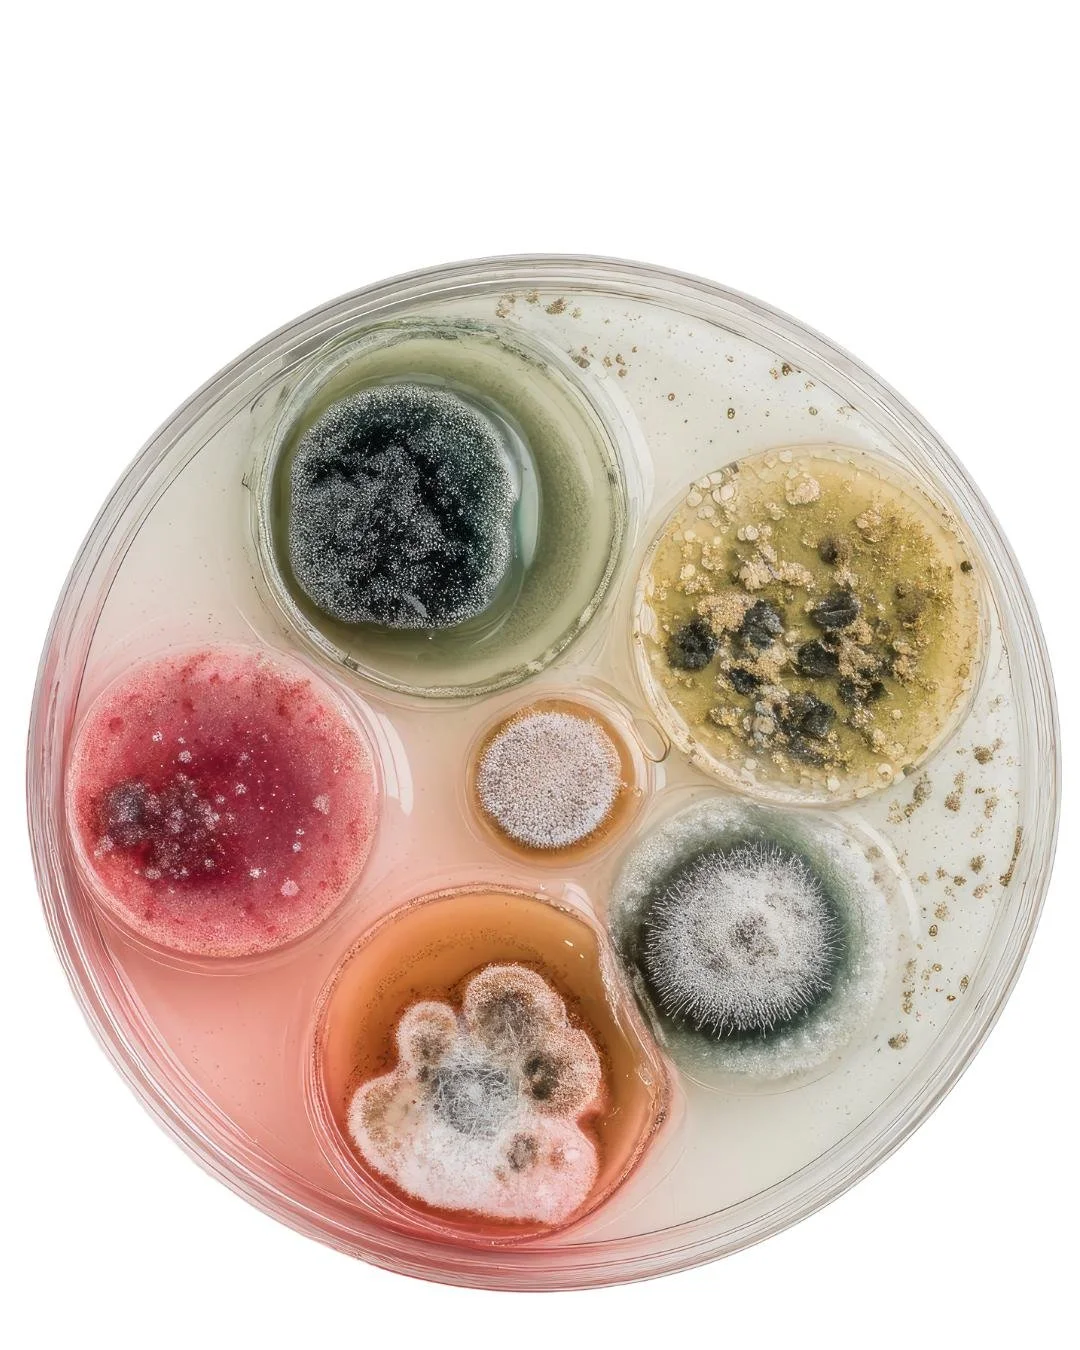

Aspergillus nei mangimi a base di semi per pappagalli: cosa dice lo studio e cosa fare in pratica
I mangimi per pappagalli e altri uccelli ornamentali possono essere contaminati da muffe microscopiche, con potenziali conseguenze serie sulla salute degli animali.
In uno studio recente (Published: 18 June 2025) su mangimi commerciali per pappagalli, quasi il 73% dei campioni è risultato contaminato da muffe – in particolare da funghi del genere Aspergillus – a dimostrazione di quanto sia diffuso il rischio.
Queste muffe non solo possono causare aspergillosi (infezioni respiratorie da spore fungine, proprio perchè i pappagalli mettendo il becco nei mangimi per nutrirsi, respirano le polveri contenute), ma producono anche micotossine: sostanze invisibili e altamente tossiche che, anche quando ingerite con il cibo, minacciano gravemente fegato, reni, sistema immunitario e altri organi degli uccelli
Le micotossine più rilevanti e i loro effetti
Le micotossine sono metaboliti tossici prodotti da Aspergillus, Fusarium, Penicillium e altri funghi . Possono contaminare i semi e i mangimi anche in assenza di muffa visibile e sono chimicamente stabili: resistono ai normali processi di lavorazione e persino alla cottura o estrusione industriale. Di seguito le principali micotossine che minacciano la salute dei pappagalli e dei volatili da compagnia
• Aflatossine (B1, B2, G1, G2) – Sintetizzate principalmente da Aspergillus flavus e A. parasiticus. L’aflatossina B1 è la più comune e tossica: è classificata dallo IARC come cancerogeno di gruppo 1 (provoca tumori epatici). Le aflatossine sono potenti epatotossine: causano necrosi delle cellule del fegato, degenerazione grassa e, nel tempo, carcinomi epatici negli uccelli e nei mammiferi. Inducono inoltre stress ossidativo e immunosoppressione, deprimendo l’attività di linfociti e macrofagi. Nei pappagalli, anche dosi croniche basse possono provocare aflatossicosi con sintomi di insufficienza epatica (anoressia, letargia, piumaggio arruffato, feci verde scuro) e predisposizione ad altre malattie.
• Ocratossina A (OTA) – Prodotta da Aspergillus ochraceus, A. carbonarius e Penicillium verrucosum, si trova su cereali, frutta secca e caffè. È una nefrotossina potente: colpisce i reni causando nefrite e gotta viscerale negli uccelli colpiti . Può ridurre l’assunzione di cibo, causare ritardi di crescita e danni renali irreversibili; inoltre è sospettata di effetti cancerogeni. Nei volatili giovani l’ocratossina è particolarmente pericolosa, e può portare a insufficienza renale acuta e morte. Anche a livelli sub-letali, provoca immunodepressione e può favorire malformazioni embrionali nelle uova di uccello.
• Fumonisine – Famiglia di tossine prodotte da Fusarium verticillioides ed altri Fusarium che contaminano soprattutto il mais. Le fumonisine (in particolare la B1 e B2) sono epato– e nefrotossiche negli avicoli 8 . Interferiscono con i lipidi di membrana delle cellule nervose: in specie sensibili causano gravi malattie neurologiche (nel cavallo provocano la leucoencefalomalacia, una degenerazione cerebrale). Nei polli e probabilmente nei pappagalli, dosi elevate di fumonisina possono determinare disordini dell’equilibrio, paralisi, edema polmonare e morte improvvisa. A livelli cronici più bassi contribuiscono a lesioni del fegato e riduzione dell’efficienza alimentare (maggior consumo di cibo per minor crescita)
• Altre tossine da Fusarium – Fusarium produce anche un ampio gruppo di tricoteceni (es. deossinivalenolo o DON, tossina T-2, diacetossiscirpenolo ecc.) e la zearalenone.
I tricoteceni inibiscono la sintesi proteica: causano irritazione e ulcerazioni gastrointestinali, diarrea e emorragie, oltre a immunosoppressione marcata.
La tossina T-2, ad esempio, provoca necrosi del becco e delle placche orali nei volatili a dosi elevate, e ha effetti citotossici su fegato e midollo osseo. La zearalenone (ZEA), invece, ha struttura simile agli estrogeni: induce sindrome estrogenica, con alterazioni del comportamento riproduttivo, infertilità e femminilizzazione dei soggetti giovani. Nei pappagalli non esistono studi specifici, ma per analogia col pollame alte dosi di ZEA possono causare prolasso cloacale, ingrossamento del tessuto riproduttivo e deposizione di uova non fertili.
Va notato che molte di queste tossine coesistono nei mangimi: la co-contaminazione da più micotossine può avere effetti sinergici aggravando la tossicità complessiva.
(Altre micotossine di interesse minore: sterigmatocistina da alcune Aspergillus, considerata precursore delle aflatossine; patulina da Penicillium su frutta; citrina da Penicillium spp., nefrotossica; acido fusarico da Fusarium, tossico per il cuore, ecc. – Queste sono meno documentate nei mangimi per uccelli, ma contribuiscono al quadro generale di rischio.)*
Per chi fosse interessato, segue l’elenco delle principali specie di muffe rilevte nei mangimi per pappagalli e uccelli
Le analisi microbiologiche di semi e mangimi per uccelli evidenziano alcuni gruppi di funghi predominanti come contaminanti:
• Aspergillus spp. – Muffe molto comuni in ambiente caldo-umido, presenti su cereali, semi oleosi e frutta secca. Aspergillus fumigatus (coinvolto nell'aspergillosi respiratoria) e altre specie come A. flavus e A. niger proliferano facilmente nei mangimi ricchi di amido e oli. Oltre a causare infezioni polmonari, alcuni Aspergilli producono aflatossine, micotossine altamente tossiche e cancerogene. Ad esempio, A. flavus e A. parasiticus sintetizzano aflatossine che possono contaminare arachidi, mais e altri semi. Le spore di Aspergillus sono piccolissime e inalabili, il che spiega la frequenza di aspergillosi aviaria.
• Fusarium spp. – Funghi tipici dei cereali coltivati e conservati. Infestano granturco (mais), frumento, orzo e altri cereali sia in campo che in magazzino. I Fusarium producono diverse micotossine pericolose: fumonisine (soprattutto nel mais), tricoteceni come deossinivalenolo (DON) e tossina T-2, e zearalenone. Queste tossine causano un ventaglio di effetti: danni al fegato, ai reni e all’intestino, nonché squilibri ormonali (ad es. zearalenone ha effetto estrogenico). Le fumonisine, ad esempio, alterano il metabolismo degli sfingolipidi e possono indurre patologie neurodegenerative (come la leucoencefalomalacia nei cavalli) oltre a lesioni epatiche. I tricoteceni invece inibiscono la sintesi proteica nelle cellule intestinali e del midollo, causando necrosi delle mucose e calo delle difese immunitarie.
• Penicillium spp. – Muffe dei depositi e silos, proliferano su granaglie stoccate in ambienti umidi. Alcune specie (es. Penicillium verrucosum) producono ocratossina A, una micotossina nefrotossica (dannosa per i reni) e immunosoppressiva. I Penicillium e Aspergillus cosiddetti “da conservazione” possono crescere anche nei sacchi di semi per uccelli se l’umidità è elevata, senza alterare visibilmente l’aspetto del mangime.
Attenzione: un cibo per pappagalli può sembrare sano all’occhio e odorare normalmente, eppure contenere livelli pericolosi di micotossine, così come può apparire ammuffito ma con tossine al di sotto della soglia di rilevabilità.
(Altre muffe meno comuni: in rari casi si segnalano anche Mucor e Alternaria nei mangimi aviari, ma con minore incidenza rispetto ai tre gruppi sopra. Tali funghi possono comunque contribuire a rovinare il cibo e, nel caso di Alternaria, produrre tossine secondarie.)
Effetti clinici e subclinici nei pappagalli
I segni clinici di un’avvelenamento da micotossine nei pappagalli possono essere subdoli e aspecifici.
Inizialmente si osservano sintomi vaghi come perdita dell’appetito, dimagrimento progressivo, piume arruffate e lieve letargia, diarrea o feci molli verdastre, polidipsia (aumento anomalo della sete) e debolezza generale.
Nel caso specifico dell’aflatossicosi cronica – una delle micotossicosi più documentate – si riscontrano in particolare segni di insufficienza epatica: apatia, perdita di peso severa, piumaggio opaco e talvolta rigurgito e aumento della sete; spesso i pappagalli tendono a mascherare il malessere fino a quando la situazione diventa grave, il che ritarda la diagnosi e il trattamento: per questa ragione ricorrete al Veterinario esperto in malattie degli psittaciformi alle prime avvisaglie.
In sintesi, gli effetti clinici delle micotossine sui psittaciformi vanno da calo delle prestazioni (crescita rallentata, problemi riproduttivi come ridotta ovodeposizione o infertilità), fino a quadri di malattia severa con danni a fegato (aflatossina, fumonisina), reni (ocratossina), apparato digerente (tricoteceni) e sistema nervoso(fumonisina, tremorgeni).
Molti di questi effetti iniziano in modo sub clinico (cioè non immeditamente visibili), ma compromettono a lungo andare la salute e la longevità del pappagallo.
Strategie di prevenzione e mitigazione
Evitare che i pappagalli entrino in contatto con mangimi contaminati è ovviamente l’obiettivo primario.
Prevenire è molto meglio che curare, dato che non esistono antidoti miracolosi per le micotossicosi e i danni spesso sono irreversibili.
Purtroppo, al momento non esistono standard di sicurezza specifici né limiti di legge chiari per le muffe nei mangimi per uccelli da compagnia, quindi la responsabilità ricade su produttori e proprietari di garantire la qualità del cibo. Cercate sempre alimenti per uso umano e di massima qualità.
Ecco alcune linee guida e misure consigliate dagli esperti per prevenire o ridurre il rischio di contaminazione da muffe e micotossine:
1) Acquistare mangimi di alta qualità da fonti affidabili:
Preferire produttori che eseguono controlli sulle materie prime e seguono buone pratiche di produzione. Miscele di semi economiche, o mangimi composti soprattutto se contengono molte arachidi, mais o frutta secca, hanno mostrato tassi più alti di contaminazione. Un prezzo elevato non garantisce sempre l’assenza di muffe, ma mangimi certificati e confezionati adeguatamente, sono quelli su cui puntare. Non acquistate misti semi polverosi, per nessuna ragione.
2) Conservare correttamente i mangimi:
L’ambiente di stoccaggio incide enormemente sulla crescita di muffe. Tenere i semi, estrusi o pellet in un luogo fresco e asciutto, al riparo dalla luce diretta del sole e dall’umidità. In alimenti di alta qualità, il produttore indica come conservarli, seguite i suoi consigli.
Normalmente il packaging ottimale incide sul costo dell’alimento, ma ne è la sua salvaguardia.
Idealmente, l’umidità del mangime dovrebbe restare sotto il 12-14%. In estate o nei climi caldi-umidi, acquistare quantitativi ridotti e non conservare il cibo per periodi prolungati: meglio rifornirsi più spesso di mangime fresco piuttosto che accumulare grandi scorte per mesi. Queste pratiche aiutano a prevenire la proliferazione di muffe durante lo stoccaggio.
3) Mantenere pulite le mangiatoie:
Residui di cibo bagnato, polvere di semi e bucce lasciati nelle ciotole possono diventare terreno di coltura per funghi e batteri. È importante rimuovere ogni giorno gli avanzi di cibo, frutta fresca o altri alimenti umidi non consumati. Anche i semi con guscio che restano a lungo nelle mangiatoie possono ammuffire se esposti a umidità (per esempio all’aperto). Cambiate il cibo ogni giorno, non lasciatelo esposto.
Lavare ogni giorno con acqua calda e sapone le ciotole e i dispensatori di cibo, asciugandoli bene prima di riempirli di nuovo. Questa buona igiene previene la contaminazione secondaria del mangime da parte di muffe ambientali.
4) assicurarsi che tutto l’ambiente in cui il pappagallo vive, sia privo di muffe: le muffe ambientali “gradiscono” e attecchiscono sul cibo esposto.
Intervenire tempestivamente in caso di sospetta contaminazione: Se si nota muffa visibile nel mangime non rischiare – eliminare subito tutto il lotto (non basta togliere la parte ammuffita, poiché le tossine possono aver contaminato in modo invisibile l’intera confezione)
In definitiva, muffe e micotossine sono nemiche silenziose nell’alimentazione dei pappagalli. Anche se spesso invisibili, i loro effetti possono essere devastanti. È responsabilità di chi si occupa di questi animali adottare un approccio prudente: fornire solo cibo di alta qualità, ben conservato e controllato, ed essere vigili nell’identificare segni di possibile contaminazione. La ricerca scientifica degli ultimi anni ha acceso i riflettori su questo problema sottostimato, auspicando l’istituzione di standard di sicurezza e procedure di screening specifiche per i mangimi destinati ai pappagalli.
Fonti: Studi scientifici e letteratura veterinaria degli ultimi anni sui mangimi aviari contaminati da micotossine, linee guida europee sulla sicurezza dei mangimi e pubblicazioni specialistiche (Frontiers in Vet. Sci. 2025, doi: 10.3389/fvets.2025.1572736 53 ; Vet. Sciences 2025, doi: 10.3390/ vetsci12060597 54 ), articoli su riviste di micotossicologia e avicoltura. (DOI e riferimenti completi disponibili nelle citazioni).